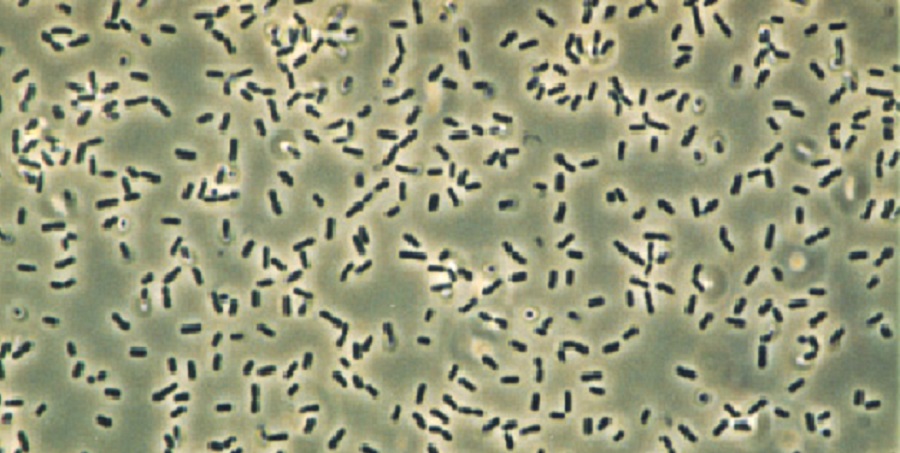
Picture background

Болезни рыб и эффективные методы профилактики

Болезни рыб и эффективные методы профилактики
Аннотация
В статье рассматривается полиэтиологическая природа заболеваний культивируемых рыб, анализируются механизмы патогенеза инфекционных и инвазионных процессов. Особое внимание уделяется переходу от химиотерапевтических методов к стратегии повышения неспецифической резистентности организма-хозяина посредством иммуномодуляции и оптимизации гидрохимического режима.
Ключевые слова: индустриальная аквакультура, ихтиопатология, эпизоотический процесс, неспецифическая резистентность, иммуномодуляция, пробиотики, аэромоноз, ихтиофтириоз, гидрохимический режим, биобезопасность.
Введение
Интенсификация товарного рыбоводства, сопровождающаяся высокими плотностями посадки гидробионтов и использованием искусственных кормов, неизбежно приводит к формированию перманентного антропогенного стресса у культивируемых объектов. Нарушение гомеостаза организма под воздействием абиотических стрессоров вызывает иммуносупрессию, что, в свою очередь, создает благоприятные условия для реализации патогенного потенциала условно-патогенной микрофлоры и облигатных паразитов. Эпизоотический процесс в аквакультуре характеризуется высокой скоростью распространения (контагиозностью) и значительной экстенсивностью инвазии или инфекции, что обусловлено водной средой как универсальным вектором передачи возбудителей. Современная ихтиопатология рассматривает болезнь не как изолированный феномен, а как результат сложного взаимодействия в системе «паразит --- хозяин --- внешняя среда», где смещение равновесия приводит к манифестации клинических признаков и летальности.
Этиология и патогенез основных групп заболеваний
В структуре заболеваемости гидробионтов доминирующее положение занимают инфекционные патологии вирусной и бактериальной этиологии, а также инвазионные болезни, вызываемые паразитическими простейшими, гельминтами и ракообразными. Бактериальные инфекции, часто провоцируемые грамотрицательными микроорганизмами родов Aeromonas, Pseudomonas и Vibrio, протекают по типу геморрагической септицемии. Патогенез данных заболеваний включает адгезию бактериальных клеток к эпителию, колонизацию тканей и выработку экзотоксинов и протеолитических ферментов, вызывающих некробиоз и лизис тканей, нарушение гемодинамики и полиорганную недостаточность. Вирусные агенты, такие как Rhabdovirus carpio (возбудитель весенней виремии карпа), обладают тропизмом к эндотелию сосудов и гемопоэтической ткани, вызывая панваскулит и деструкцию почечной паренхимы.

Особую категорию представляют протозоозы, среди которых наиболее патогенным является Ichthyophthirius multifiliis, вызывающий ихтиофтириоз. Жизненный цикл данного реснитчатого инфузории включает стадии трофонта (паразитирующего в эпителии), томонта (цисты размножения во внешней среде) и теронта (инвазионной бродяжки). Массивная инвазия приводит к гиперплазии эпителия жабр, нарушению газообмена, осморегуляторной дисфункции и асфиксии. В отличие от инфекционных агентов, многие эктопаразиты обладают сложным жизненным циклом, что требует дифференцированного подхода к прерыванию путей передачи на различных стадиях онтогенеза возбудителя. Грибковые заболевания, или микозы (в частности, сапролегниоз, вызываемый оомицетами семейства Saprolegniaceae), чаще всего выступают в роли секундарной инфекции, развиваясь на травмированных участках тегумента или икры при снижении иммунного статуса и нарушении гидрохимических показателей, таких как рН и окисляемость воды.

Методология профилактики и терапевтические подходы
Современная парадигма ветеринарно-санитарных мероприятий в аквакультуре смещается от реактивной терапии антибиотиками и антигельминтиками к превентивной стратегии управления здоровьем стада. Основу профилактики составляет строгий карантинный режим для вновь поступающего посадочного материала, исключающий горизонтальную трансмиссию возбудителей. Критически важным элементом является мониторинг гидрохимических параметров и проведение регулярного ихтиопатологического скрининга для раннего выявления асимптоматического носительства.
В контексте биологических методов защиты все большее распространение получает иммунопрофилактика, включающая вакцинацию против специфических вирусных и бактериальных агентов, а также использование пробиотиков и иммуностимуляторов. Введение в рацион штаммов-пробионтов (например, Bacillus subtilis, Lactobacillus spp.) способствует колонизации кишечника полезной микрофлорой, обеспечивая конкурентное вытеснение патогенов и продукцию бактериоцинов. Механизм действия иммуномодуляторов (бета-глюканов, нуклеотидов) основан на активации факторов неспецифической резистентности: повышении фагоцитарной активности лейкоцитов, увеличении титра лизоцима и системы комплемента в сыворотке крови, а также стимуляции синтеза цитокинов.
Технологические методы профилактики в системах с замкнутым водоснабжением (УЗВ) включают механическую фильтрацию воды для удаления цистных стадий паразитов (например, томонтов ихтиофтириуса), использование ультрафиолетового облучения и озонирования для инактивации свободноживущих стадий патогенов. При возникновении вспышек заболеваний применяются терапевтические ванны с использованием органических красителей, формалина или солевых растворов, однако их применение строго регламентируется во избежание токсического воздействия на жаберный аппарат рыб и биофильтрацию системы.
Заключение
Эффективное управление эпизоотическим благополучием рыбоводного предприятия требует комплексного подхода, интегрирующего методы экологической оптимизации среды обитания, генетической селекции на резистентность к заболеваниям и современных биотехнологических способов иммунокоррекции. Минимизация использования ксенобиотиков и переход к экологически безопасным методам профилактики являются необходимым условием для обеспечения устойчивого развития аквакультуры и получения продукции высокого санитарного качества.
Список источников:
Головина, Н. А. Ихтиопатология / Н. А. Головина, Ю. А. Стрелков, В. Н. Воронин. --- М.: Мир, 2018. --- 448 с.
Пищенко, Е. В. Болезни рыб и основы рыбоводной санитарии: учебное пособие / Е. В. Пищенко, А. А. Морозов. --- СПб.: Лань, 2020. --- 236 с.
Бычкова, Л. И. Охрана здоровья рыб как важнейшее условие эффективной аквакультуры: методические рекомендации / Л. И. Бычкова. --- Пенза: РИО ПГАУ, 2019. --- 45 с.
Текебаева, Ж. Б. Пробиотики и их применение в аквакультуре: современное состояние и перспективы / Ж. Б. Текебаева // Инновации в сельском хозяйстве. --- 2020. --- № 3. --- С. 112--118.
Гаврилин, К. В. Современные подходы к специфической профилактике инфекционных болезней рыб / К. В. Гаврилин // Рыбоводство и рыбное хозяйство. --- 2021. --- № 5. --- С. 34--40.
Юхименко, Л. Н. Проблемы бактериальных болезней рыб в условиях тепловодных хозяйств и методы их решения / Л. Н. Юхименко, Г. С. Койдан // Ветеринария сегодня. --- 2019. --- Т. 7, № 2. --- С. 56--61.
Сayman, J. Fish Health Management in Recirculating Aquaculture Systems / J. Cayman, P. J. Southgate. --- London: Academic Press, 2022. --- 312 p.


